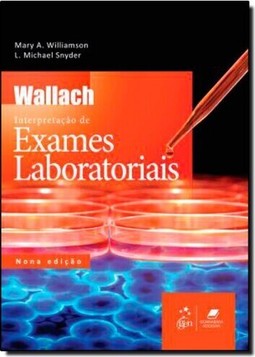

CADASTRE-SE
Sinopse
A nona edição de Wallach Interpretação de Exames Laboratoriais foi totalmente revisada e atualizada por uma nova equipe de autores e colaboradores do Department of Hospital Laboratories/UMass Memorial Medical Center, sem, contudo, perder a tradição dos en
| Categoria | |
| Editora | GUANABARA KOOGAN |
| ISBN-13 | 9788527722308 |
| ISBN | 8527722305 |
| Edição | 1 / 2013 |
| Idioma | Português |
| Páginas | 1004 |
| Estante | 0 0 0 0 |
| Sua estante | |
4% chance de ser solicitado
CADASTRE-SE
AVALIAÇÃO DO LEITOR
Quero comentar sobre este livro